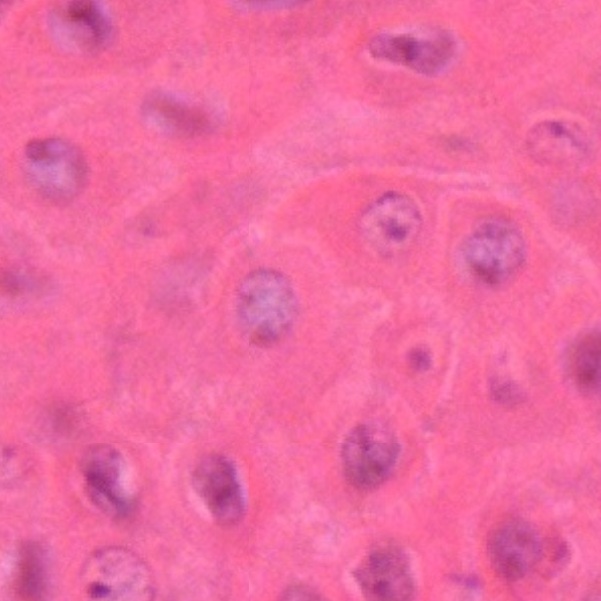
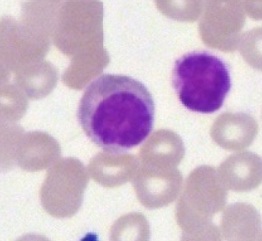
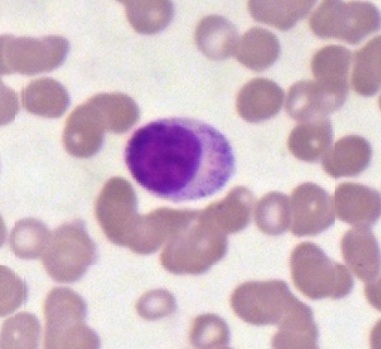
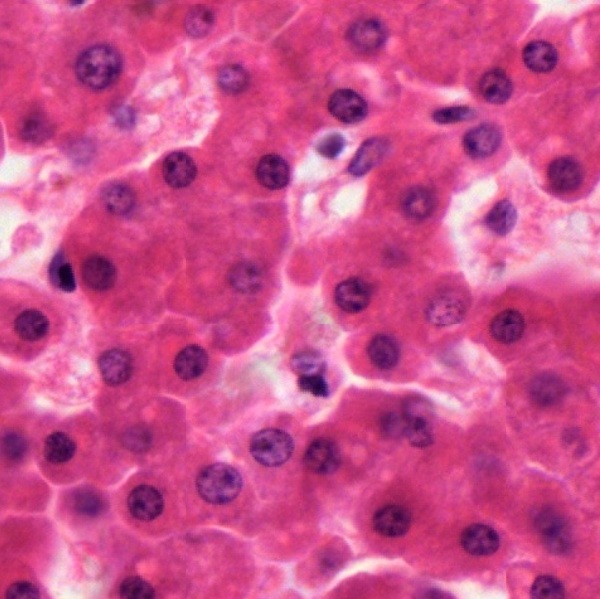
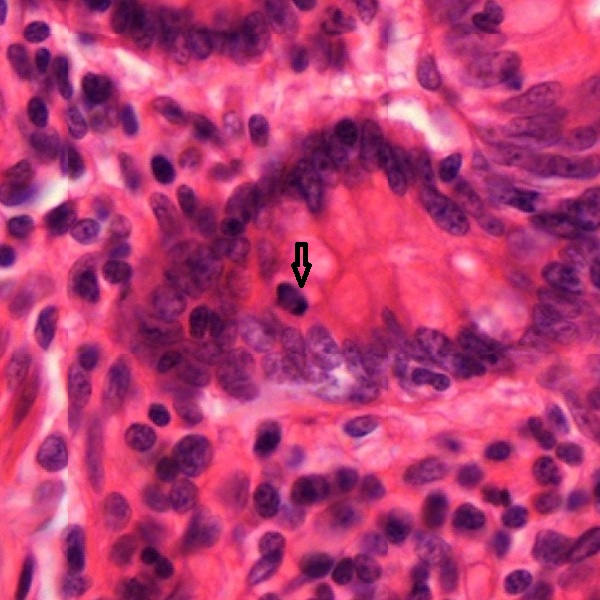

The cell is not only structural but also functional unit of all living organisms. In the human body, as a multicellular organism, the cells show a great variety of sizes and forms. Despite this variation, all cells conform to a general morphology and cellular components, called cellular organelles. Observation of cellular organelles at light microscopic level is never an easy task. Certain organelles can only be visible after histochemical stains which are limited to vital tissue.
Cell Membrane
It is also known as cytoplasmic membrane , plasma membrane , or plasmalemma. The cell membrane forms a selective and structural barrier between extracellular space and cytoplasm. It cannot be structurally visible at light microscopic level but can be distinguished from the surroundings in the following preparations: oral mucous cells (Fig. 1-1), liver cells (Fig. 1-2), motor neurons of spinal cord (Fig. 1-3), and acinar cells of sublingual gland (Fig.1-4). All photos are taken with a 40X objective lens.
In a whole mount preparation of frog mesentery with silver impregnation, a layer of mesothelium composed of simple squamous epithelium can be observed under the light microscope (Figs. 1-5 and 1-6). At higher magnification with a 40X objective lens (Figs.1-7 and 1-8), in each coarse mesh flat and polygonal fine meshes with unsmooth borders (arrow) can be observed. These unsmooth borders represent the existence of cell membranes even they are invisible at the light microscopic level. The squamous epithelial cells are seen to be packed closely with almost no intercellular space but stained cellular outline. Inside the squamous epithelial cells cell nuclei (N) can be seen as unstained oval spots.
Cytoplasm
The cytoplasm is composed of ground substance, cytoskeleton, cellular organelles, and certain inclusions. The ground substance is a gelatinous liquid and is invisible at light microscopic level. The existence of the cytoplasm can only be judged by the space between cell membrane and cell nucleus as shown in the following preparations: oral mucous cell (Fig. 1-9), prickle cells of skin stratum spinosum (Fig. 1-10), ganglion cells of spinal ganglion (Fig. 1-11), parietal (oxyntic) cells and chief (zymogenic) cells of gastric gland (Fig.1-12). They are stained with routine hematoxylin-eosin but have different cytoplasmic appearance due to variation of cytoplasmic contents. Oral mucous cell has pinkish cytoplasm with dense spots which could be organelles and inclusions. Prickle cells bear intercellular bridges and present eosinophilic cytoplasm in contrast to basophilic nuclei. The huge ganglion cell (Fig. 1-11) not only has eosinophilic cytoplasm, but also contains basophilic spots assumed to be Nissl bodies which are aggregates of rough endoplasmic reticulum. Red-colored cytoplasm of parietal cells (arrow) reflects their acidic content. Blue-colored cytoplasm of chief cells reflects their enzyme content. All photos are taken with a 40X objective lens.
Cytoskeleton
There are three components of cytoskeleton found in human cells, microtubules, microfilaments or thin filaments, and intermediate filaments. They cannot be easily identified at light microscopic level with routine hematoxylin-eosin stain. In a section of spinal cord stained with hematoxylin-eosin, there are eosinophilic fibrous structures which are not only seen in a dendrite (Fig. 1-13) but also filled in observable field (Figs. 1-13 and 1-14) in contrast to basophilic cell nuclei. Their staining is due to the presence of neurofilaments, one of the intermediate filaments. If the section of spinal cord is processed with silver impregnation, then these fibrous structures become blackened with brown ground (Fig. 1-15). In a cell undergoing mitosis (Fig. 1-16), spindle fibers (arrow) are found to extend from centrosomes (C) and anchor the chromosomes (Ch) in place.
Both centrosomes and spindle fibers are made up of microtubules.
Cellular Organelles
Mitochondrion
Mitochondria are membrane-bound cell organelles that generate most of the chemical energy needed to power the cell’s biochemical reactions.They are composed of an outer membrane and an inner membrane. The intermembrane space is in between the two membranes, while the inner membrane is folded to form cristae and encloses a matric space. All these structures can be seen clearly at electron microscopic level. At light microscopic level, if mitochondria are elongated and aggregated then they can be identified even after a routine staining with hematoxylin and eosin. Both Figures 1-17 and 1-18 show cross sections of striated ducts in a human parotid gland. The striations (arrow) in the basal aspect of each duct cell are made up of mitochondria. In a section of frog liver stained with iron hematoxylin, in contrast to dark-stained nuclei, there are many thread-like lightly stained organelles (Figs. 1-19 and 1-20) inside each hepatic cell. They are mitochondria.
Golgi apparatus
A Golgi apparatus is named after its discoverer, Camillo Golgi, also known as Golgi complex. It is a cell organelle that helps process and package proteins and lipid molecules, especially proteins destined to be exported from the cell. At EM level, it is found to be composed of a specifically oriented cluster of vesicles, tubules, and flattened membrane-bound cisternae. At light microscopic level, in a marrow smear prepared with Wright’s stain, the cytoplasm of developing leukocytes is packed with rough endoplasmic reticulum for protein synthesis and is basophilic. There are pale unstained areas (arrow) in the cytoplasm of the developing leukocytes (Figs. 1-21 and 1-22), indicating the presence of Golgi complex (Golgi apparatus) whose lipid component is dissolved during preparation. The Golgi cisternae can be visible at light microscopic level in a section of mammalian ganglion prepared with a silver stain. Inside the ganglion cell bodies (Figs. 1-23 and 1-24), there are numerous darkened vermiform organelles (arrow) surrounding clear zones of cell nuclei. They are Golgi cisternae.
Endoplasmic reticulum
The endoplasmic reticulum (ER) is a network of interconnected tubules and flattened sacs (cisternae) extending throughout the cytoplasm within the cell. If it is associated with ribosomes, it is named as rough ER, otherwise named as smooth ER. Because of the basophilic nature of rough ER, it can be identified as spotty aggregate in the cytoplasm. In nerve cell body these aggregates of rough ER are numerous and apparent to form Nissl bodies or Nissl substances. They are clearly visualized under light microscopic in the cell bodies of spinal motor neuron (Fig. 1-25) and Purkinje cell (Fig. 1-26) after staining with cresyl violet, or even in the cell bodies of spinal ganglion cell (Fig. 1-27) and spinal motor neuron (Fig. 1-28) with routine hematoxylin-eosin stain.
Centrosome and Centrioles
The centrosome is composed of two centrioles perpendicular to each other. It is in the cell adjacent to the cell nucleus and plays as a microtubule organizing center (MTOC). It cannot be observed at light microscopic level but appears to be visible during cell division when two centrioles (arrows) move toward opposite poles of the dividing cell (Figs. 1-29 and 1-30). The centrosome is also involved in the formation of cilia and flagella. At the cilial base of trachea epithelial cells (Fig. 1-31) and epithelial cells of oviduct (Fig. 1-32) densely stained connected lines (arrow) can be seen under the light microscope. These lines are made up of basal bodies of cilia and junctional complex between epithelial cells. Both cilia and basal bodies contain microtubules and have similar structures to centrioles.
Certain organelles such as endosomes, lysosomes, and peroxisomes cannot be easily identified through routine histological processes under the light microscope. Their electron micrographs with description are available in most histology textbooks and atlases.
Inclusions
Cell inclusions are non-membrane bound stored materials and do not have active metabolic roles like organelles. The common visible inclusions under the light microscope include glycogen granules in liver cells (Fig. 1-33), lipid droplets in adipocytes (Fig. 1-34), pigment granules (Fig. 1-35) and keratin granules (Fig. 1-36) in skin cells, and pigment epithelium of eye layers (Fig. 1-37), lipofuscin granules in ganglion cells (Fig. 1-38), and secretory products in acinar cells of parotid gland (Figs. 1-39), goblet cells (G) of intestinal epithelium (1-40) and other epithelial glands. Details about these inclusions will be discussed in the following related chapters.
Cell Nucleus
It acts as the control center of the cell and contains nucleolus and long strands of chromosomes. Like cell membrane, the nuclear membrane is also a double membrane. It encloses the nucleus and separates its contents from the cytoplasm. While the nuclear membrane is invisible under the light microscope, nucleolus and chromosomes are distinguishable. Both make up the nucleoplasm. The sizes and shapes of cell nuclei (pleural form of nucleus) are found to be variable: oval nuclei (arrow) in skeletal muscle fibers (Fig. 1-41), columnar nuclei toward the free surface in intestinal epithelial cells (Fig. 1-42), spherical nucelli in liver cells (Fig. 1-43), and fusiform nuclei (arrow) in fibroblasts (Fig. 1-44). Despite the morphological variation, all nuclei have a central nucleolus with strands of chromosomes enclosed by the nuclear membrane.
Chromosomes
Humans typically have 23 pairs of chromosomes, or 46 chromosomes. These chromosomes contain genetic information that determines human characteristics. Twenty-two of these pairs are autosomes. They are the same in both males and females. The 23rd pair, the sex chromosomes, differ between males (XY) and females (XX). To observe human chromosomes under the light microscope, cultured human blood lymphocytes are prepared to break the nuclei and spread on glass slide, followed by staining with Giemsa stain. Figures 1-45 and 1-46 show male chromosomes. Figures 1-47 and 1-48 show female chromosomes.
In human body, each cell type has its own life span. Some cells may be replaced every few days and others may last a lifetime. For example, intestinal epithelial cells last only 5 days, and skin cells replace every few weeks. Some nerve cells can last a lifetime; others may still go through turnover. Except the germ cells, all human cells continue to replicate by cell division, also known as mitosis. Following mitosis, the daughter cells enter a period of growth before further mitotic division. The time interval between mitosis, the life cycle of an individual cell, is called the cell cycle. Cell division and cell growth is balanced by cell death through a mechanism know as apoptosis during the development and maturation of the human body.
Cell Division
Cell division or mitosis can be observed in many cell types under the light microscope. Among the short-lived cells, intestinal epithelial cells are chosen here. In sections of human intestines with routine hematoxylin-eosin staining, some epithelial cells are found to undergo cell division (Figs. 1-49 ~ 1-52) ). Epithelial cells undergo mitosis reveal broken nuclei with obvious aggregates of chromosome strands (arrow).
To illustrate each phase of mitosis, a section ascaris ova stained by iron hematoxylin is used here due it its large cell size. The sequence of mitotic division can be seen as follows: Interphase (Fig. 1-53), early prophase (Fig. 1-54), late prophase(Fig. 1-55), metaphase (Fig. 1-56), early anaphase (Fig. 1-57), late anaphase (Fig. 1-58), early telophase (Fig. 1-59), late telophase (Fig. 1-60).
Apoptosis
As stated above, apoptosis, or programmed cell death, is a natural process occurring in the human body from time to time for cell renewal. Apoptotic cells can be identified in all tissues at light microscopic level by the appearance of empty cytoplasm, condensed and even fragmented nuclei. In the preparation of oral mucous epithelium (Figs. 1-61 and 1-62), many dying cells can be observed. In tissue composed of the short-lived cells such as intestinal epithelium (Figs. 1-63 and 1-64), apoptotic cells (arrow) are also easily identified.
NOTE:
- Only those organelles visible under the light microscope are discussed here. It is suggested that to study all organelles visible under the electron microscope through your histology textbook and atlas.
- All photos used for discussion are taken from DSMH and DSAH digital slides as follows:
H010010 Male Oral Epithelium, smear of scrape from male mouth, HE. (Figs. 1-1, 1-61, 1-62)
H010020 Female Oral Epithelium, smear of scrapings from female mouth, HE. (Fig. 1-9)
H010030 Male Chromosomes, prepared from male lymphocytes, human, GS. (Figs. 1-45, 1-46)
H010040 Female Chromosomes, prepared from female lymphocytes, human, GS. (Figs. 1-47, 1-48)
H010050 Golgi Complex, sec. of mammalian ganglion, SI. (Figs. 1-23, 1-24)
H010060 Mitochondria, sec. of frog liver, IH. (Figs. 1-19, 1-20)
H010090 Nissl Bodies, cs. of spinal cord, human, CV. (Fig. 1-25)
H010101 Goblet Cell, cs. of jejunum, mammal, HE. (Fig. 1-40)
H010110 Mitosis, sec. of Ascaris ova, IH. (Figs. 1-16, 1-29, 1-30, 1-53 ~1-60)
H020021 Simple Squamous Epithelium, surface view of frog mesentery, wm., SI. (Figs. 1-5 ~ 1-8)
H030020 Adipose Tissue, sec., human, HE. (Fig. 1-34)
H040020 Skeletal Muscle, ls. & cs., human, HE. (Fig. 1-41)
H050060 Spinal Ganglion, ls., human, HE. (Figs. 1-11, 1-27)
H050070 Sympathetic Ganglion, ls., human, HE. (Fig. 1-38)
H050080 Spinal Cord, cs., human, HE. (Figs. 1-3, 1-13, 1-14, 1-28)
H050082 Spinal Cord Cervical, cs., human, SI. (Fig. 1-15,)
H050160 Cerebellar Cortex, sec. of folia, human, CV. (Fig. 1-26)
H070091 Bone Marrow, smear, human, GS. (Figs. 1-21, 1-22)
H080010 Thick Skin, sec. of sole skin, human, HE. (Figs. 1-10, 1-35, 1-36, 1-44)
H090070 Parotid Gland, sec., human, HE. (Figs. 1-17, 1-18, 1-39)
H090090 Sublingual Gland, sec., human, HE. (Fig. 1-4)
H090160 Cardiac Stomach, sec., human, HE. (Fig. 1-12)
H090210 Jejunum, cs., human, HE. (Figs. 1-42, 1-49, 1-50)
H090220 Ileum, cs., human, HE. (Fig. 1-51)
H090230 Small Intestine Composite, cs. of three intestine portions, human, HE. (Figs. 1-52, 1-63, 1-64)
H090300 Liver, sec., human, HE. (Figs. 1-2, 1-43)
H090302 Liver, sec. showing glycogen, human, PAS. (Fig. 1-33)
H100020 Trachea, cs., human, HE. (Fig. 1-31)
H110200 Fallopian Tube, sec., human, HE. (Fig. 1-32)
H130030 Eye, sec., primate, HE. (Fig. 1-37) - Staining methods and results:
CV = cresyl violet, as methylene blue, is used to stain rough endoplasmic reticulum to show clumps of Nissl substance, or Nissl bodies which are dark blue in contrast to pale blue of background cytoplasm.
GS = Giemsa stain, is commonly used to stain blood cells and cellular elements in other smear preparation such as bone marrow. Nuclei are stained dark blue to violet, background cytoplasm pale blue and erythrocytes pale pink.
HE = hematoxylin and eosin, is used to stain cell nuclei blue and cytoplasm pink or red. Hematoxylin may also stain ribosomes and rough endoplasmic reticulum blue.
IH = iron hematoxylin, is used to visualize mitochondria which are greyish brown. It can also be for staining elastic and collagen fibers.
SI = silver impregnation, is used to demonstrate neurons and processes in black or brown.